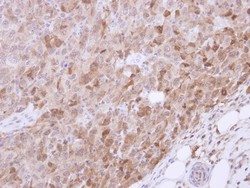

Antibody data
- Antibody Data
- Antigen structure
- References [1]
- Comments [0]
- Validations
- Western blot [2]
- Immunohistochemistry [4]
Submit
Validation data
Reference
Comment
Report error
- Product number
- NBP2-20857 - Provider product page

- Provider
- Novus Biologicals
- Product name
- Rabbit Polyclonal VIAAT/SLC32A1/VGAT Antibody
- Antibody type
- Polyclonal
- Description
- Immunogen affinity purified.
- Reactivity
- Human, Mouse, Rat
- Host
- Rabbit
- Isotype
- IgG
- Vial size
- 0.1 ml
- Storage
- Aliquot and store at -20C or -80C. Avoid freeze-thaw cycles.
Submitted references Involvement of the Acyl-CoA binding domain containing 7 in the control of food intake and energy expenditure in mice.
Lanfray D, Caron A, Roy MC, Laplante M, Morin F, Leprince J, Tonon MC, Richard D
eLife 2016 Feb 15;5
eLife 2016 Feb 15;5
No comments: Submit comment
Supportive validation
- Submitted by
- Novus Biologicals (provider)
- Main image

- Experimental details
- Western Blot: VIAAT/SLC32A1/VGAT Antibody [NBP2-20857] - Non-transfected (-) and transfected (+) Boiled and unboiled HeLa whole cell extracts (30 ug) were separated by 10% SDS-PAGE, and the membrane was blotted with VGAT antibody [N1N2], N-term diluted at 1:5000. The HRP-conjugated anti-rabbit IgG antibody (NBP2-19301) was used to detect the primary antibody.
- Submitted by
- Novus Biologicals (provider)
- Main image

- Experimental details
- Western Blot: VIAAT/SLC32A1/VGAT Antibody [NBP2-20857] - Non-transfected (-) and transfected (+) 293T whole cell extracts (30 ug) were separated by 10% SDS-PAGE, and the membrane was blotted with VGAT antibody [N1N2], N-term diluted at 1:5000. The HRP-conjugated anti-rabbit IgG antibody was used to detect the primary antibody.
Supportive validation
- Submitted by
- Novus Biologicals (provider)
- Main image
- Experimental details
- Immunohistochemistry-Paraffin: VGAT Antibody [NBP2-20857] - Immunohistochemical analysis of paraffin-embedded CL1-5 xenograft, using antibody at 1:500 dilution.
- Submitted by
- Novus Biologicals (provider)
- Main image

- Experimental details
- Immunohistochemistry-Paraffin: VIAAT/SLC32A1/VGAT Antibody [NBP2-20857] - Paraffin-Embedded adult mouse retina. Green: VGAT protein stained by VGAT antibody [N1N2], N-term diluted at 1:250. Red: beta Tubulin 3/ TUJ1, stained by beta Tubulin 3/ TUJ1 antibody [11710] (NBP2-43559) diluted at 1:500. Blue: Fluoroshield with DAPI.
- Submitted by
- Novus Biologicals (provider)
- Main image

- Experimental details
- Immunohistochemistry-Frozen: VIAAT/SLC32A1/VGAT Antibody [NBP2-20857] - Frozen-sectioned adult mouse cerebellum. Green: VGAT protein stained by VGAT antibody [N1N2], N-term diluted at 1:250. Red: beta Tubulin 3/ TUJ1, stained by beta Tubulin 3/ TUJ1 antibody [11710] (NBP2-43559) diluted at 1:500. Blue: Fluoroshield with DAPI.
- Submitted by
- Novus Biologicals (provider)
- Main image

- Experimental details
- Immunohistochemistry-Frozen: VIAAT/SLC32A1/VGAT Antibody [NBP2-20857] - Frozen sectioned adult mouse retina. Green: VGAT protein stained by VGAT antibody [N1N2], N-term diluted at 1:250. Red: beta Tubulin 3/ TUJ1, stained by beta Tubulin 3/ TUJ1 antibody [11710] (NBP2-43559) diluted at 1:250. Blue: Fluoroshield with DAPI.